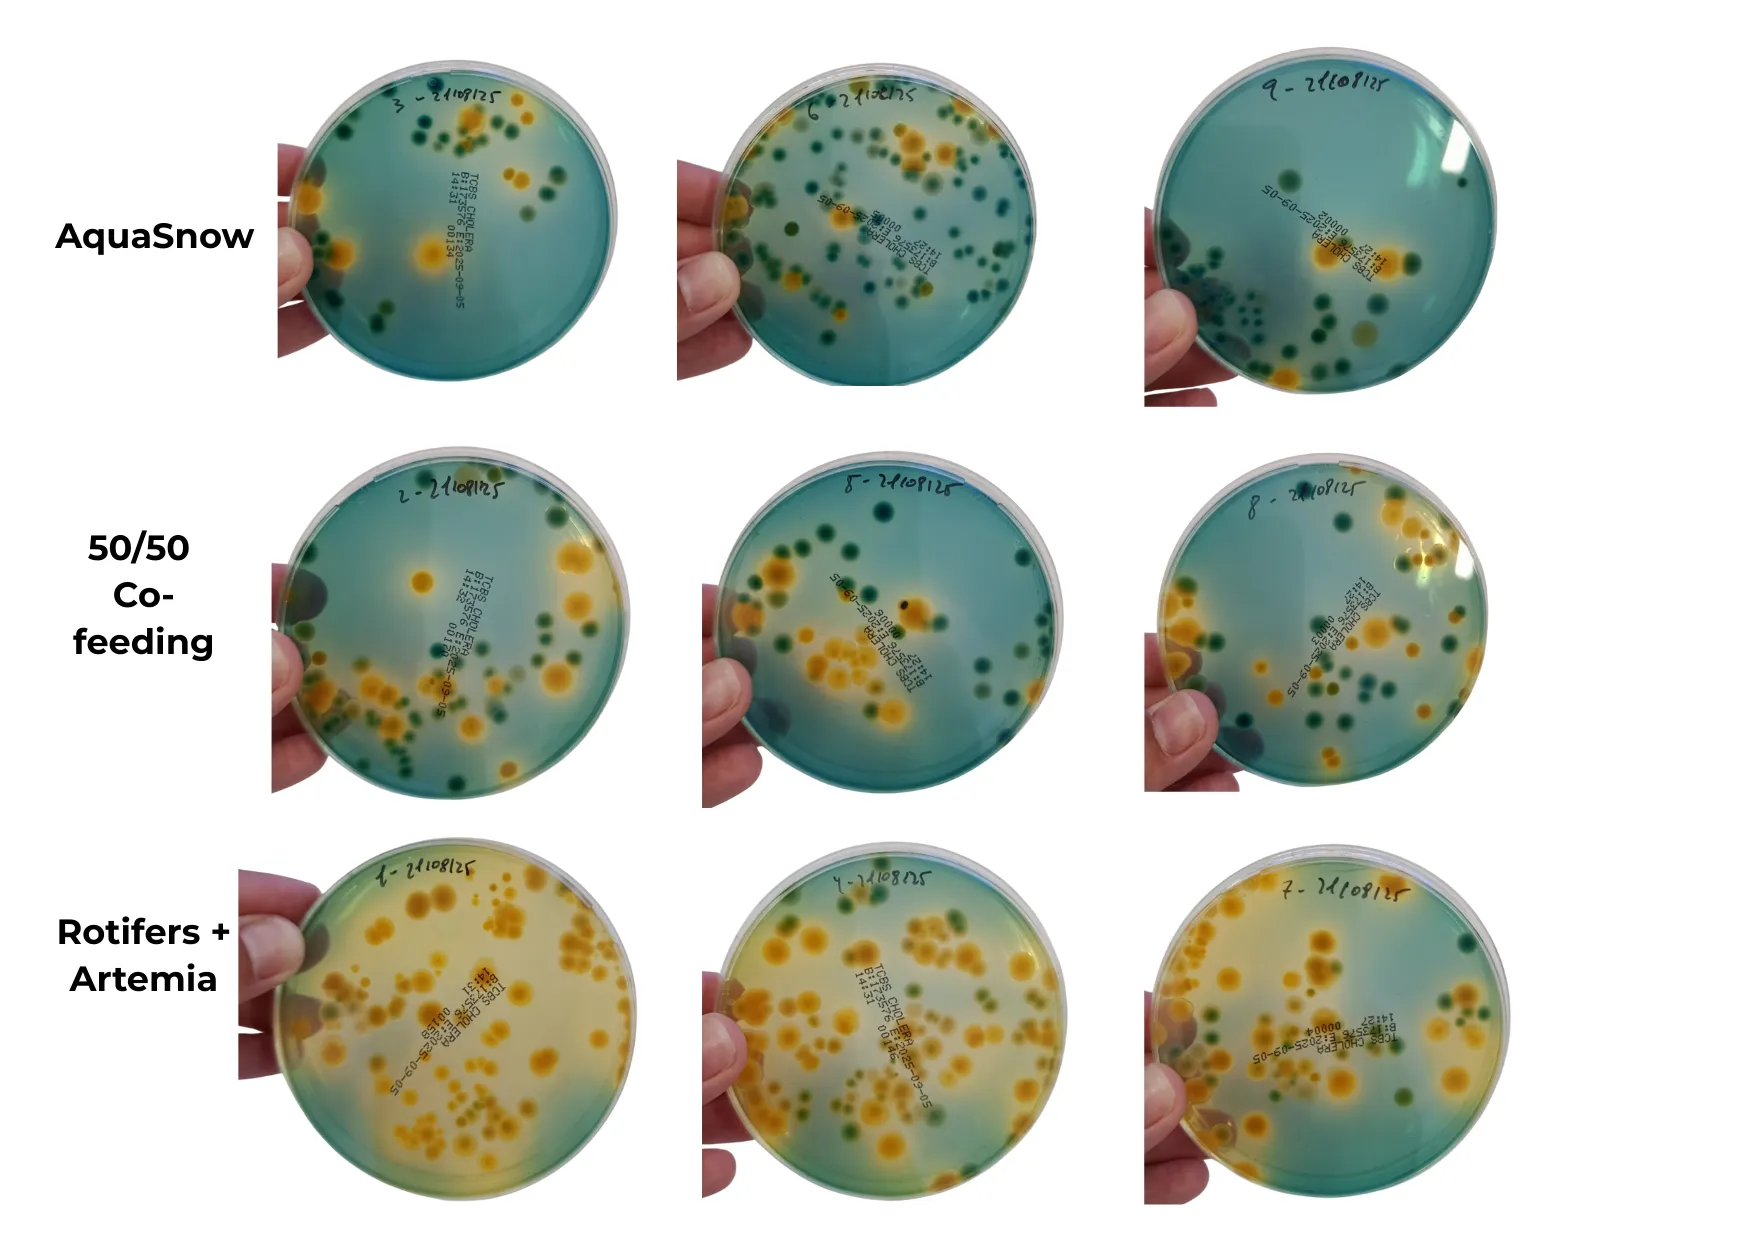
agar plates showing vibrio colonies in yellow

From R&D to Field Validation: AquaSnow’s Journey
When we first began working on AquaSnow more than four years ago, we were chasing a vision that many in aquaculture have long hoped for: a practical alternative to live feeds in hatchery production.
Live feeds like rotifers, Artemia, and algae are indispensable for rearing marine fish and shellfish larvae, yet they come with challenges. They are costly to produce, sometimes unpredictable in availability, and sensitive to environmental changes that affec future global supply. Hatchery managers know the constant balancing act keeping live cultures going, maintaining biosecurity, and controlling costs.
Our team believed there was a better way. If hatcheries could rely on a stable, ready to use feed, it would not only reduce the risks and labor involved in live feed production but also make hatchery operations more efficient and sustainable. The challenge, however, was enormous: larvae are notoriously selective. Getting them to accept an artificial diet (let alone thrive on it) has been one of aquaculture’s greatest technical hurdles.
The Early Years: Trial and Error
The first stage of AquaSnow was heavily focused on research. We experimented with prototypes of prototypes, testing how different formulations, particle sizes, and physical properties could lead to something edible.
Early versions failed: larvae ignored them, or performance dropped compared to live feeds. But we learned from every experience.
Progress was slow but steady. Each iteration brought us closer to a formula that larvae could accept. By 2024, our trials were showing promising results — not perfect yet, but enough to prove that the concept was possible.
The key breakthrough was in replicating not only the nutritional value of live feeds, but demonstrating that larvae could eat and digest the AquaSnow diet without succumbing to deteriorating water quality.
The Breakthrough Moment
This year, we reached two milestones:
- In an in vivo trial, we documented European seabass larvae chasing and consuming the diet.
- Later, this summer, in controlled larval trials with European seabass, AquaSnow was offered as the sole diet — with no live feed supplementation for 10 days — larvae grew from 4 days post hatch (dph) to 14 dph.
The results were clear: survival rates matched those of traditional live feed diets, and larvae displayed normal growth and feeding behavior.

Even more striking were the operational benefits. Hatchery staff reported:
- Cleaner water
- Lower microbial loads
- Easier management
With live feeds, hatcheries often struggle with the constant need for monitoring and cleaning due to waste, surface oil films, overfeeding, or culture crashes. AquaSnow simplified the process, reducing stress both for the larvae and for the people running the hatchery.
This means for hatcheries:
- Less dependency on fragile supply chains for Artemia
- Less reliance on costly rotifer and algae production
- Lower risk of production losses from live feed culture crashes
- More predictable and scalable operations
- Improved water quality and biosecurity, translating into healthier larvae
In other words, AquaSnow is a step toward transforming how hatcheries produce larvae. We believe the future of hatchery feeding is within reach!
What Comes Next
While we are proud of these first breakthroughs, our journey is far from complete. The next phase will be validation in real-world conditions:
- Larger tanks
- More larvae
- Trial durations beyond 30 days
- Extending into the weaning period and beyond
- Tuning AquaSnow’s nutritional profile
Stay Connected
You can stay up to date with us by checking this blog blog and our LinkedIn page.